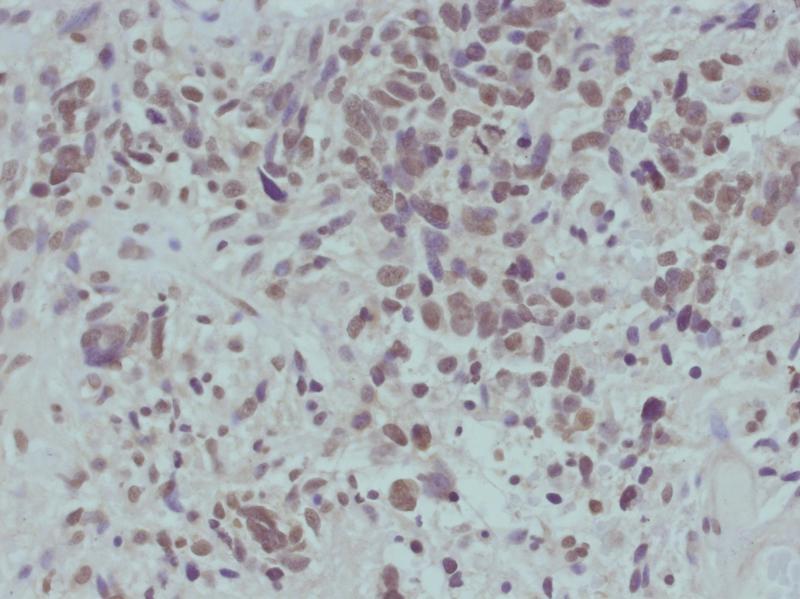

beta-catenin (Phospho-Ser715) Antibody
Figure 1: Immunohistochemical analysis of paraffin-embedded human primary glioblastoma multiforme (GBM) specimens using beta-catenin (Phospho-Ser715) Antibody 35-1358 .
Roll over image to zoom in
Shipping Info:
For estimated delivery dates, please contact us at [email protected]
Amount : | 100 µl |
Purification : | Affinity-chromatography |
Content : | Supplied at 1.0mg/mL in phosphate buffered saline (without Mg2+ and Ca2+), pH 7.4, 150mM NaCl, 0.02% sodium azide and 50% glycerol. |
Storage condition : | Store at 4°C; For long-term storage; store at -20°C. Avoid repeated freeze and thaw cycles. |
Key downstream component of the canonical Wnt signaling pathway. In the absence of Wnt, forms a complex with AXIN1, AXIN2, APC, CSNK1A1 and GSK3B that promotes phosphorylation on N-terminal Ser and Thr residues and ubiquitination of CTNNB1 via BTRC and its subsequent degradation by the proteasome. In the presence of Wnt ligand, CTNNB1 is not ubiquitinated and accumulates in the nucleus, where it acts as a coactivator for transcription factors of the TCF/LEF family, leading to activate Wnt responsive genes. Involved in the regulation of cell adhesion. Acts as a negative regulator of centrosome cohesion. Involved in the CDK2/PTPN6/CTNNB1/CEACAM1 pathway of insulin internalization. Blocks anoikis of malignant kidney and intestinal epithelial cells and promotes their anchorage-independent growth by down-regulating DAPK2. Disrupts PML function and PML-NB formation by inhibiting RANBP2-mediated sumoylation of PML
Western blotting: 1:500~1:1000
For Research Use Only. Not for use in diagnostic/therapeutics procedures.
Subcellular location: | Cytoplasm, Nucleus, Cytoplasm, Cell junction, Cell junction, Cell membrane, Cytoplasm, Cytoplasm, Cell junction, Cytoplasm |
Post transnational modification: | Deacetylated at Lys-49 by SIRT1. |
Tissue Specificity: | Expressed in several hair follicle cell types: basal and peripheral matrix cells, and cells of the outer and inner root sheaths. Expressed in colon. Present in cortical neurons (at protein level). Expressed in breast cancer tissues (at protein level) (PubMed:29367600). |
BioGrid: | 107880. 630 interactions. |
There are currently no product reviews
|